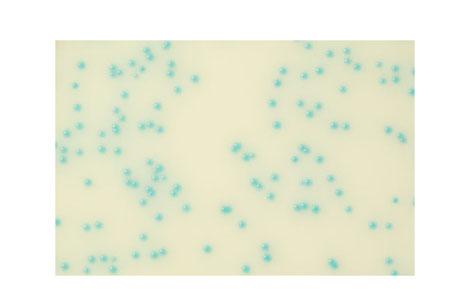
RAPID'Listeria spp. Medium | Bio-Rad Laboratories
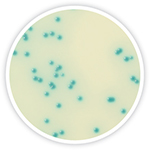
RAPID'Listeria spp. Medium | Bio-Rad Laboratories

描述
RAPID’Listeria spp. Medium is an affordable selective chromogenic agar for the detection of Listeria spp. in food and environmental samples.
Key Benefits
- Fast and cost effective
- Only 1 broth and 1 plate are required per sample
- Results after just 24 hr of incubation for all Listeria species after 24 hr enrichment
- High specificity and selectivity
- Easy-to-read chromogenic reaction based on the specific b-glucosidase activity of Listeria
- Blue color for all Listeria spp.
- Reading and differentiation are easy due to the contrast between blue-green Listeria colonies and the whitish agar
- The selectivity and high nutrient content of the medium prevent growth of interfering flora
- Validation
- Certified NF VALIDATION according to the ISO 16140 standard
- Validated by AOAC
- Easy Confirmation
- Single spot inoculation on RAPID’L.mono agar (+Gram and catalase tests) or on Palcam has been validated for confirmation
Principle
Identification of Listeria spp. using RAPID’Listeria spp. chromogenic medium is based on the detection of β‑D‑glucosidase activity by a chromogenic substrate. Listeria colonies are blue to bluish-green. The medium is made selective by the combined action of lithium chloride and an antibiotic mixture inhibiting Bacillus and all interfering flora.
Listeria spp. Monitoring: Preventing Listeria monocytogenes Contamination
When Listeria gets into food, it often comes from environmental contamination. Finding sources of contamination by Listeria spp. in the processing plant is the first step towards preventing Listeria monocytogenes contamination of food.
A proactive, aggressive environmental monitoring program is needed as a first step in preventing contamination. The RAPID’Listeria spp. method of environmental monitoring can improve the chances of finding where Listeria spp. exist in the environment and reducing the risk of food contamination.
RAPID’Listeria spp. Chromogenic Assay

| Enzymatic Activity |  Listeria spp. |
|---|---|
| β-D-Glucosidase | + |
Ordering Information
RAPID’Listeria spp. Medium is offered as a dehydrated agar base (3564744). When preparing the medium from the dehydrated base, RAPID’Listeria spp. Supplement 1 (3564745) and Supplement 2 (3564746) need to be added to the molten agar prior to pouring plates.
Related Products
-
iQ-Check Listeria spp. PCR Detection Kit
技术指标
订购
items
Use the filters below to refine results!

3564744

3564745

3564746

3555797

3564604

3564616
3563674
3564754
3564752
3555792
3555794

3578113

3578124
相关资料
Login Required
RAPID'Listeria spp., User Guide (English, French, German, Italian, Portuguese, Spanish)
RAPID’Chromogenic Media Brochure
Food Safety and Quality Reference Guide
Complete Solutions for Service Laboratories
